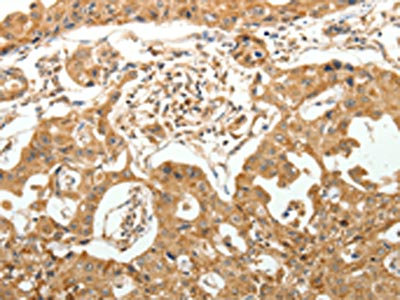

MAP1B Antibody
-
中文名稱:MAP1B兔多克隆抗體
-
貨號:CSB-PA218026
-
規格:¥1100
-
圖片:
-
The image on the left is immunohistochemistry of paraffin-embedded Human ovarian cancer tissue using CSB-PA218026(MAP1B Antibody) at dilution 1/40, on the right is treated with synthetic peptide. (Original magnification: ×200)
-
The image on the left is immunohistochemistry of paraffin-embedded Human lung cancer tissue using CSB-PA218026(MAP1B Antibody) at dilution 1/40, on the right is treated with synthetic peptide. (Original magnification: ×200)
-
-
其他:
產品詳情
-
Uniprot No.:
-
基因名:MAP1B
-
別名:FUTSCH antibody; LC1 antibody; MAP-1B antibody; MAP1 light chain LC1 antibody; Map1b antibody; MAP1B_HUMAN antibody; MAP5 antibody; Microtubule associated protein 1B antibody; Mtap1b antibody; Mtap5 antibody
-
宿主:Rabbit
-
反應種屬:Human,Mouse,Rat
-
免疫原:Synthetic peptide of Human MAP1B
-
免疫原種屬:Homo sapiens (Human)
-
標記方式:Non-conjugated
-
抗體亞型:IgG
-
純化方式:Antigen affinity purification
-
濃度:It differs from different batches. Please contact us to confirm it.
-
保存緩沖液:-20°C, pH7.4 PBS, 0.05% NaN3, 40% Glycerol
-
產品提供形式:Liquid
-
應用范圍:ELISA,IHC
-
推薦稀釋比:
Application Recommended Dilution ELISA 1:3000-1:10000 IHC 1:50-1:200 -
Protocols:
-
儲存條件:Upon receipt, store at -20°C or -80°C. Avoid repeated freeze.
-
貨期:Basically, we can dispatch the products out in 1-3 working days after receiving your orders. Delivery time maybe differs from different purchasing way or location, please kindly consult your local distributors for specific delivery time.
-
用途:For Research Use Only. Not for use in diagnostic or therapeutic procedures.
相關產品
靶點詳情
-
功能:Facilitates tyrosination of alpha-tubulin in neuronal microtubules. Phosphorylated MAP1B may play a role in the cytoskeletal changes that accompany neurite extension. Possibly MAP1B binds to at least two tubulin subunits in the polymer, and this bridging of subunits might be involved in nucleating microtubule polymerization and in stabilizing microtubules. Acts as a positive cofactor in DAPK1-mediated autophagic vesicle formation and membrane blebbing.
-
基因功能參考文獻:
- All of the patients with a microtubule associated protein 1B (MAP1B) variant had a similar brain abnormality, and at least one of the parents who transmitted the variant to their child was also similarly affected. PMID: 29738522
- MAP1B heavy chain has a unique binding site for a calcium-binding protein ALG-2. PMID: 29432744
- These results suggest that a change in the intracellular calcium level plays a role in regulation of the secretory pathway via interaction of ALG-2 with MISSL and MAP1B. PMID: 28864773
- The found of this study suggested that possible roles of MAP1B genes in working memory performance in ADHD patients PMID: 26233433
- KIRREL3 interacting proteins MAP1B and MYO16 are potential candidates for intellectual disability and autism spectrum disorder. PMID: 25902260
- signal transduction pathways downstream of 5-HT6R are regulated by MAP1B, which might play a role in 5-HT6R-mediated signaling in the brain. PMID: 24614691
- The the MAP1B-LC1-mediated regulation most likely involves an internalization of the channels via a dynamin and clathrin-dependent pathway. PMID: 25483588
- An interaction between MAP1B LC1 and the ubiquitin-conjugating enzyme UBE2L3. PMID: 24566975
- Localization of MAP1B is altered in amyotrophic lateral sclerosis spinal cords in a transgenic animal model. PMID: 25429138
- Yeast-two-hybrid screening using human LRRK2 kinase domain as bait identified microtubule associated protein 1B (MAP1B) as a LRRK2 interactor. PMID: 24754922
- We suggest a role for Stau2 in the generation and regulation of Map1b mRNA containing granules that are required for mGluR-long-term depression PMID: 21508097
- These observations define a new and crucial function of MAP1B that is required for efficient cross-talk between microtubules and the actin cytoskeleton during neuronal polarization. PMID: 20719958
- MAP1B action is modulated by mapmodulin/leucine-rich acidic nuclear protein PMID: 12807913
- The light chain (LC1) of microtubule-associated protein 1B (MAP1B)-5-HT(3A) receptor interaction contributes to a mechanism that regulates receptor desensitization kinetics. PMID: 18063656
- Amyloid-beta 1-42 binds to a peptide comprising the microtubule binding domain of the heavy chain of microtubule-associated protein 1B by the screening of a human brain cDNA library expressed on M13 phage. PMID: 18079022
- a role for MAP1B in DAPK-1-dependent signaling in autophagy and membrane blebbing. PMID: 18195017
- MAP1B light chain can interact with the tumor suppressor p53. PMID: 18656471
- a new protein involved in the terminal differentiation of odontoblasts PMID: 19567321
顯示更多
收起更多
-
亞細胞定位:Cytoplasm, cytoskeleton. Cytoplasm. Cell junction, synapse. Cell projection, dendritic spine.; [MAP1 light chain LC1]: Cytoplasm.
-
蛋白家族:MAP1 family
-
數據庫鏈接:
Most popular with customers
-
-
YWHAB Recombinant Monoclonal Antibody
Applications: ELISA, WB, IHC, IF, FC
Species Reactivity: Human, Mouse, Rat
-
-
-
-
-
-